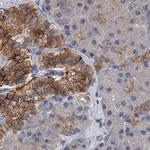
NBEA Antibody in Immunohistochemistry (IHC)

Search
Invitrogen
NBEA Polyclonal Antibody
{{$productOrderCtrl.translations['antibody.pdp.commerceCard.promotion.promotions']}}
{{$productOrderCtrl.translations['antibody.pdp.commerceCard.promotion.viewpromo']}}
{{$productOrderCtrl.translations['antibody.pdp.commerceCard.promotion.promocode']}}: {{promo.promoCode}} {{promo.promoTitle}} {{promo.promoDescription}}. {{$productOrderCtrl.translations['antibody.pdp.commerceCard.promotion.learnmore']}}

Please note: We are reviewing Western blot images included in the antibody testing data in our catalog, including those provided by third parties. Unless expressly labeled or annotated as “raw-unedited”, Western blot images included in the antibody testing data in our catalog may have been edited, optimized or otherwise adjusted for presentation.
产品信息
PA5-58903
种属反应
已发表种属
宿主/亚型
分类
类型
抗原
偶联物
形式
浓度
规格
纯化类型
保存液
内含物
保存条件
运输条件
RRID
产品详细信息
Immunogen sequence: ETTRTGSQPG RNIRQEINSP TSTVVVIPSI PHPSLNHGFL AKLIPEQSFG HSFYKETPAA FPDTIKEKET PTPGEDIQVE SSIPHTDSGI GEEQVASILN GAELETSTGP DAMSEL
Highest antigen sequence identity to the following orthologs: Mouse - 89%, Rat - 25%.
靶标信息
This gene encodes a member of a large, diverse group of A-kinase anchor proteins that target the activity of protein kinase A to specific subcellular sites by binding to its type II regulatory subunits. Brain-specific expression and coat protein-like membrane recruitment of a highly similar protein in mouse suggest an involvement in neuronal post-Golgi membrane traffic. Mutations in this gene may be associated with a form of autism. This gene and its expression are frequently disrupted in patients with multiple myeloma. Alternative splicing results in multiple transcript variants encoding distinct isoforms. Additional transcript variants may exist, but their full-length nature has not been determined.
仅用于科研。不用于诊断过程。未经明确授权不得转售。
生物信息学
蛋白别名: FLJ10197; Lysosomal-trafficking regulator 2; Neurobeachin; Protein BCL8B; RP11-270C18.1
基因别名: BCL8B; KIAA1544; LYST2; NBEA
Entrez Gene ID: (Human) 26960




